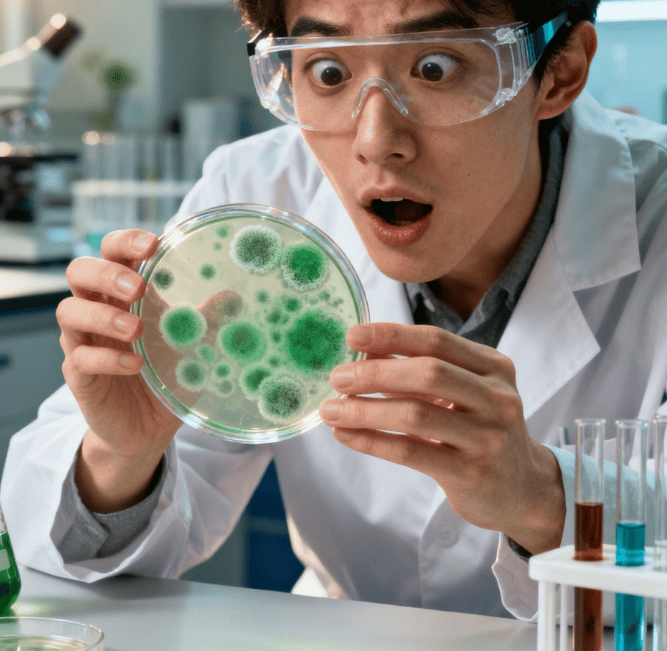
青霉素的发现：弗莱明实验室最值钱的 “邋遢”

青霉素的发现:弗莱明实验室最值钱的 “邋遢”
1928 年秋,亚历山大・弗莱明推开实验室门时,估计自己都皱了眉。俩礼拜前赶著去海滨度假,实验台压根没收拾 —— 玻璃培养皿摞得歪歪扭扭,里面的 “金妖精” 葡萄球菌还敞着,桌上甚至能看见半根没抽完的香烟。换作别的研究员,八成第一时间就把这堆乱摊子清了,可他偏不。
“糟了,长霉了!” 第五个培养皿拿起来时,他突然喊出声。青绿色的霉斑爬得到处都是,正常人早扔了,弗莱明却盯着看了半天。你别说,就这一眼,看出了天大的名堂 —— 霉斑周围居然空了一圈,他养了好久的金黄色葡萄球菌,全没了踪影!
后来我才知道,这可不是弗莱明第一次 “因乱得福”。之前他感冒流鼻涕,随手滴进培养皿也没收拾,结果发现鼻涕周围细菌全死了,顺着这线索还发现了人体里的溶菌酶。跟那些实验完必擦得一尘不染的同事比,他的台子简直像被台风扫过,可偏偏是这种 “邋遢”,让他总能撞见别人忽略的细节。
他赶紧把那点霉菌刮下来放显微镜下看,确认是青霉菌。接着疯了似的测试 —— 把培养液稀释了一遍又一遍,哪怕稀释到八百分之一,“金妖精” 照样死光光。更神的是,白喉菌、炭疽菌这些狠角色,碰上这东西也没辙。1929 年他就发了论文,可当时谁也没当回事,连他自己都没意识到这玩意儿能救人性命。
真正把这霉菌变成 “救命药” 的,是后来的弗洛里和钱恩。听说他们为了提纯青霉素,找了一堆女孩培养霉菌,牛津大学能装水的东西全用上了,烧杯、浴缸堆得像山,那场面估计比弗莱明的实验室还乱。最巧的是,有个研究员在菜市场看见个发霉的哈密瓜,觉得那霉长得 “奇怪”,捡回去一测,居然能把青霉素剂量提上千倍!
现在想想多后怕,要是弗莱明当时随手扔了那培养皿,要是那研究员嫌哈密瓜脏不捡,多少人要栽在感染上?以前的人得了个疖肿、脑膜炎就可能没命,青霉素出来后,人类平均寿命都涨了不少。弗莱明自己倒挺谦虚,说 “是大自然创造了青霉素,我只不过发现了它”。
不过说真的,这 “发现” 也挑人。实验室里其他人肯定也见过发霉的培养皿,可只有他停下来较真了。那些被当成 “邋遢” 的杂乱,那些没按规矩来的疏忽,反倒成了打通生路的钥匙。有时候真觉得,科学这东西,太讲究工整反而容易错过惊喜。

评论